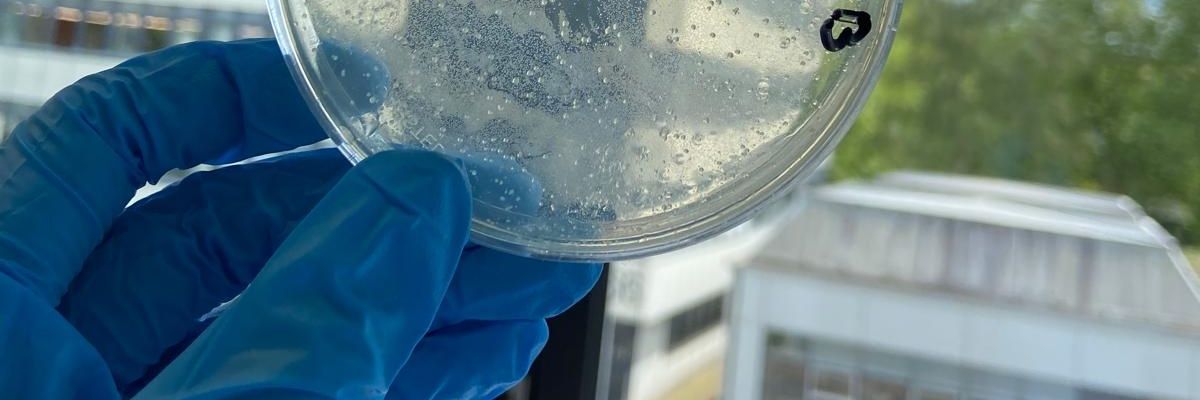
Der Örtliche Virologe banner

Sabitlenmiş Tweet

When your little #biochem 'Chloroplast'-excursion ends as a master-class in #organicchemistry...

English
Der Örtliche Virologe
1.2K posts

@k778115
Chem. Bio. & Virologie 🇩🇪 🇪🇺 ✠ FCK Links-, Rechts-, und jeglichen anderen Extremistmus















